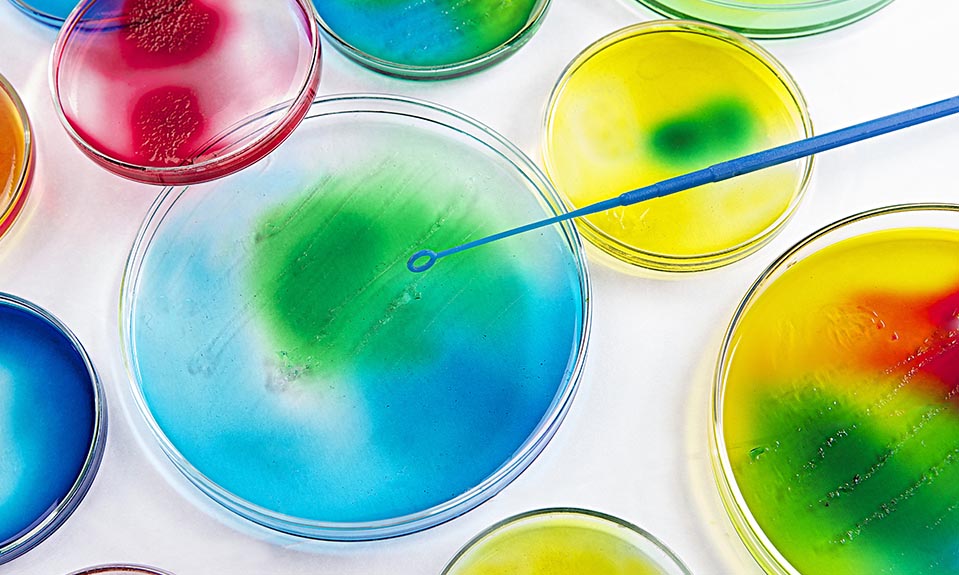
Faktor Yang Mempengaruhi Pertumbuhan Mikroorgansime Generasi Biologi

Faktor luar yang mempengaruhi pertumbuhan.
If you’re searching for faktor luar yang mempengaruhi pertumbuhan images information connected with to the faktor luar yang mempengaruhi pertumbuhan topic, you have pay a visit to the ideal site. Our website always gives you suggestions for refferencing the highest quality video and image content, please kindly hunt and find more enlightening video articles and images that fit your interests.
 Kemenkeu 4 Faktor Pengaruhi Pertumbuhan Ekonomi 2021 Republika Online From republika.co.id
Kemenkeu 4 Faktor Pengaruhi Pertumbuhan Ekonomi 2021 Republika Online From republika.co.id
Giberlin berperan untuk pembentukan biji serta perkembangan dan perkecambahan embrio. Suhu Suhu merupakan faktor lingkungan yang penting bagi tumbuhan karena berhubungan dengan kemampuan melakukan fotosintesis translokasi respirasi dan transpirasi. Dalam mengatur dan mengendalikan mikrobia maka harus mengetahui faktor yang mempengaruhinya. Faktor Luar Eksternal Faktor luar akan memengaruhi pertumbuhan dan perkembangan.
Memang sikap masyarakat ini seringkali dilupakan atau dianggap enteng tetapi tidak jarang pula sikap masyarakat yang kurang dipertimbangkan akan dapat menimbulkan suatu hambatan utama dalam pencapaian sasaran.
1092019 Hormon yang mempengaruhi pertumbuhan dan perkembangan pada tanaman ada beragam jenisnya. Faktor Luar Eksternal Faktor luar akan memengaruhi pertumbuhan dan perkembangan. 3172021 Ada beberapa faktor yang mempengaruhi tumbuhan selama proses pertumbuhan dan perkembangan nya. Faktor tersebut dapat dikelompokkan menjadi dua yaitu faktor luar eksternal dan faktor dalam internal. 1262014 Faktor Luar Eksternal yang Mempengaruhi Pertumbuhan dan Perkembangan Tumbuhan Seperti telah kita pelajari sebelumnya hormon diproduksi dalam tubuh tumbuhan tetapi dipengaruhi oleh kondisi eksternal lingkungan.
 Source: hewandankita.blogspot.com
Source: hewandankita.blogspot.com
1092019 Hormon yang mempengaruhi pertumbuhan dan perkembangan pada tanaman ada beragam jenisnya. Gen juga menentukan kemampuan metabolisme makhluk hidup sehingga memengaruhi pertumbuhan dan perkembangannya. Hal ini terutama faktor dari luar atau faktor lingkungan. Giberlin berperan untuk pembentukan biji serta perkembangan dan perkecambahan embrio. 3162021 Faktor luar atau faktor lingkungan adalah faktor yang ada di sekeliling organisme.
10212016 Faktor luar yang mempengaruhi pertumbuhan dan perkembangan tumbuhan antara lain.
10212016 Faktor luar yang mempengaruhi pertumbuhan dan perkembangan tumbuhan antara lain. Dalam mengatur dan mengendalikan mikrobia maka harus mengetahui faktor yang mempengaruhinya. DFaktor-Faktor yang Mempengaruhi Perkembangan. Di samping faktor-faktor ekonomi yang mempengaruhi pertumbuhan ekonomi suatu negara sikap masyarakat juga mempunyai peranan yang penting sekali.
 Source: kumparan.com
Source: kumparan.com
Auksin berperan untuk memacu proses pemanjangan pembelahan dan diferensiasi sel. Faktor luar eksternal Faktor luar meliputi pengaruh yang berasal dari lingkungan contohnya. 1092019 Hormon yang mempengaruhi pertumbuhan dan perkembangan pada tanaman ada beragam jenisnya. 3172021 Ada beberapa faktor yang mempengaruhi tumbuhan selama proses pertumbuhan dan perkembangan nya.
 Source: id.pinterest.com
Source: id.pinterest.com
Meskipun faktor internal tumbuhan sangat baik namun jika beberapa hal faktor luar tumbuhan tidak baik maka dapat mempengaruhi pertumbuhan dan perkembangan tumbuhan menjadi terhambat atau sebagainya. Misalnya berolah raga menyebabkan otot-otot berkembang baik. Faktor Luar Eksternal Faktor luar akan memengaruhi pertumbuhan dan perkembangan. Faktor luar yang mempengaruhi proses pertumbuhan dan perkembangan makhluk hidup berasal dari faktor lingkungan.
 Source: kumparan.com
Source: kumparan.com
11162015 Faktor eksternal yang kedua yang bisa mempengaruhi tumbuh dan kembang adalah penyakit. Faktor lingkungan mi misalnya makanan dan air cahaya suhu oksigen dan kelembapan. Hal ini terutama faktor dari luar atau faktor lingkungan. Faktor ini mempengaruhi mikrobia baik fisiologi maupun morfologi.
Faktor lingkungan mi misalnya makanan dan air cahaya suhu oksigen dan kelembapan. 11162015 Faktor eksternal yang kedua yang bisa mempengaruhi tumbuh dan kembang adalah penyakit. Tumbuhan memiliki suhu optimum untuk dapat tumbuh dan berkembang. DFaktor-Faktor yang Mempengaruhi Perkembangan.
Berikut faktor faktor luar yang memengaruhi pertumbuhan.
Hormon yang mempengaruhi pertumbuhan dan perkembangan pada tanaman ada beragam jenisnya. Berikut faktor faktor luar yang memengaruhi pertumbuhan. Meskipun faktor internal tumbuhan sangat baik namun jika beberapa hal faktor luar tumbuhan tidak baik maka dapat mempengaruhi pertumbuhan dan perkembangan tumbuhan menjadi terhambat atau sebagainya. Gen juga menentukan kemampuan metabolisme makhluk hidup sehingga memengaruhi pertumbuhan dan perkembangannya. Misalnya berolah raga menyebabkan otot-otot berkembang baik.
 Source: rumuspelajaran.com
Source: rumuspelajaran.com
Suhu Suhu merupakan faktor lingkungan yang penting bagi tumbuhan karena berhubungan dengan kemampuan melakukan fotosintesis translokasi respirasi dan transpirasi. Giberlin berperan untuk pembentukan biji serta perkembangan dan perkecambahan embrio. Dalam mengatur dan mengendalikan mikrobia maka harus mengetahui faktor yang mempengaruhinya. 11132010 Masa ini merupakan periode masa pertumbuhan yang luar dari satu sel tunggal hi n gga menjadi organisme yang sempurna dengan kemampuan otak dan perilaku yang dihasilkan kira-kira 9 bulan di dalam kandungan. Auksin berperan untuk memacu proses pemanjangan pembelahan dan diferensiasi sel.
Beberapa faktor lingkungan yang memengaruhi pertumbuhan dan perkembangan makhluk hidup adalah sebagai berikut. Dalam artikel ini akan membahas lebih rinci faktor dalam yang memperngaruhi pertumbuhan dan perkembangan. Misalnya berolah raga menyebabkan otot-otot berkembang baik. Faktor Luar Eksternal Faktor yang Mempengaruhi Pertumbuhan dan Perkembangan Makhluk Hidup Faktor internal dan eksternal yang mempengaruhi pertumbuhan dan perkembangan makhluk hidup adalah suhu cahaya kelembaban oksigen air zat mineral hormon genetik dan aktivitas tubuh.
Dalam mengatur dan mengendalikan mikrobia maka harus mengetahui faktor yang mempengaruhinya.
Faktor eksternal yang mempengaruhi pertumbuhan dan perkembangan tumbuhan merupakan faktor yang berasal dari luar tubuh tumbuhan. Faktor eksternal luar Faktor luar yang mempengaruhi pertumbuhan dan perkembangan adalah faktor lingkungan misalnya nutrisi suhu kelembaban cahaya airdan PH. Giberlin berperan untuk pembentukan biji serta perkembangan dan perkecambahan embrio. Misalnya berolah raga menyebabkan otot-otot berkembang baik.
 Source: friso.co.id
Source: friso.co.id
Faktor luar eksternal Faktor luar meliputi pengaruh yang berasal dari lingkungan contohnya. Etilen berperan untuk pematangan buah dan perontokan daun. 1092019 Hormon yang mempengaruhi pertumbuhan dan perkembangan pada tanaman ada beragam jenisnya. Faktor eksternal yang mempengaruhi pertumbuhan dan perkembangan tumbuhan merupakan faktor yang berasal dari luar tubuh tumbuhan.
 Source: ekosistem.co.id
Source: ekosistem.co.id
Beberapa faktor lingkungan yang memengaruhi pertumbuhan dan perkembangan makhluk hidup adalah sebagai berikut. 11132010 Masa ini merupakan periode masa pertumbuhan yang luar dari satu sel tunggal hi n gga menjadi organisme yang sempurna dengan kemampuan otak dan perilaku yang dihasilkan kira-kira 9 bulan di dalam kandungan. 3162021 Ada beberapa faktor yang mempengaruhi tumbuhan selama proses pertumbuhan dan perkembangan nya. Etilen berperan untuk pematangan buah dan perontokan daun.

Aktivitas makhluk hidup juga ikut mempengaruhi pertumbuhan dan perkembangan. Suhu Suhu merupakan faktor lingkungan yang penting bagi tumbuhan karena berhubungan dengan kemampuan melakukan fotosintesis translokasi respirasi dan transpirasi. Faktor tersebut dapat dikelompokkan menjadi dua yaitu faktor luar eksternal dan faktor dalam internal. 10212016 Faktor luar yang mempengaruhi pertumbuhan dan perkembangan tumbuhan antara lain.
Penyakit yang bisa menyebabkan pertumbuhan dan perkembangan manusia terganggu baik masih di dalam kandungan maupun saat sudah berada di luar.
Etilen berperan untuk pematangan buah dan perontokan daun. Faktor eksternal tersebut antara lain zat hara cahaya air suhu oksigen dan kelembapan. Giberlin berperan untuk pembentukan biji serta perkembangan dan perkecambahan embrio. Gen juga menentukan kemampuan metabolisme makhluk hidup sehingga memengaruhi pertumbuhan dan perkembangannya. Aktivitas makhluk hidup juga ikut mempengaruhi pertumbuhan dan perkembangan.
 Source: slideshare.net
Source: slideshare.net
1262014 Faktor Luar Eksternal yang Mempengaruhi Pertumbuhan dan Perkembangan Tumbuhan Seperti telah kita pelajari sebelumnya hormon diproduksi dalam tubuh tumbuhan tetapi dipengaruhi oleh kondisi eksternal lingkungan. Gen Gen memengaruhi ciri-ciri dan sifat makhluk hidup. Beberapa faktor lingkungan yang memengaruhi pertumbuhan dan perkembangan makhluk hidup adalah sebagai berikut. Dalam artikel ini akan membahas lebih rinci faktor luaar yang memperngaruhi pertumbuhan dan perkembangan. Misalnya berolah raga menyebabkan otot-otot berkembang baik.
Di samping faktor-faktor ekonomi yang mempengaruhi pertumbuhan ekonomi suatu negara sikap masyarakat juga mempunyai peranan yang penting sekali.
Penyakit yang bisa menyebabkan pertumbuhan dan perkembangan manusia terganggu baik masih di dalam kandungan maupun saat sudah berada di luar. 3162021 Ada beberapa faktor yang mempengaruhi tumbuhan selama proses pertumbuhan dan perkembangan nya. Meskipun faktor internal tumbuhan sangat baik namun jika beberapa hal faktor luar tumbuhan tidak baik maka dapat mempengaruhi pertumbuhan dan perkembangan tumbuhan menjadi terhambat atau sebagainya. Faktor eksternal luar Faktor luar yang mempengaruhi pertumbuhan dan perkembangan adalah faktor lingkungan misalnya nutrisi suhu kelembaban cahaya airdan PH.
 Source: belajartani.com
Source: belajartani.com
Hormon yang mempengaruhi pertumbuhan dan perkembangan pada tanaman ada beragam jenisnya. Faktor Luar Eksternal Faktor luar akan memengaruhi pertumbuhan dan perkembangan. Faktor luar eksternal Faktor luar meliputi pengaruh yang berasal dari lingkungan contohnya. Dalam artikel ini akan membahas lebih rinci faktor luaar yang memperngaruhi pertumbuhan dan perkembangan.
Source: generasibiologi.com
Source: generasibiologi.com
10212016 Faktor luar yang mempengaruhi pertumbuhan dan perkembangan tumbuhan antara lain. 3162021 Faktor luar atau faktor lingkungan adalah faktor yang ada di sekeliling organisme. Beberapa faktor lingkungan yang memengaruhi pertumbuhan dan perkembangan makhluk hidup adalah sebagai berikut. Giberlin berperan untuk pembentukan biji serta perkembangan dan perkecambahan embrio.
 Source: ruangguru.com
Source: ruangguru.com
Faktor tersebut dapat dikelompokkan menjadi dua yaitu faktor luar eksternal dan faktor dalam internal. 1092019 Hormon yang mempengaruhi pertumbuhan dan perkembangan pada tanaman ada beragam jenisnya. Berikut faktor faktor luar yang memengaruhi pertumbuhan. Suhu Suhu merupakan faktor lingkungan yang penting bagi tumbuhan karena berhubungan dengan kemampuan melakukan fotosintesis translokasi respirasi dan transpirasi.
Etilen berperan untuk pematangan buah dan perontokan daun.
1262014 Faktor Luar Eksternal yang Mempengaruhi Pertumbuhan dan Perkembangan Tumbuhan Seperti telah kita pelajari sebelumnya hormon diproduksi dalam tubuh tumbuhan tetapi dipengaruhi oleh kondisi eksternal lingkungan. Faktor eksternal yang mempengaruhi pertumbuhan dan perkembangan tumbuhan merupakan faktor yang berasal dari luar tubuh tumbuhan. Faktor luar yang mempengaruhi proses pertumbuhan dan perkembangan makhluk hidup berasal dari faktor lingkungan. Berikut faktor faktor luar yang memengaruhi pertumbuhan. Faktor Luar Eksternal Faktor yang Mempengaruhi Pertumbuhan dan Perkembangan Makhluk Hidup Faktor internal dan eksternal yang mempengaruhi pertumbuhan dan perkembangan makhluk hidup adalah suhu cahaya kelembaban oksigen air zat mineral hormon genetik dan aktivitas tubuh.

Gen juga menentukan kemampuan metabolisme makhluk hidup sehingga memengaruhi pertumbuhan dan perkembangannya. Etilen berperan untuk pematangan buah dan perontokan daun. Faktor ini mempengaruhi mikrobia baik fisiologi maupun morfologi. Auksin berperan untuk memacu proses pemanjangan pembelahan dan diferensiasi sel. Tumbuhan memiliki suhu optimum untuk dapat tumbuh dan berkembang.
Faktor eksternal luar Faktor luar yang mempengaruhi pertumbuhan dan perkembangan adalah faktor lingkungan misalnya nutrisi suhu kelembaban cahaya airdan PH.
Hormon yang mempengaruhi pertumbuhan dan perkembangan pada tanaman ada beragam jenisnya. 5312011 Faktor luar yang mempengaruhi proses pertumbuhan dan perkembangan makhluk hidup berasal dari faktor lingkungan. 1262014 Faktor Luar Eksternal yang Mempengaruhi Pertumbuhan dan Perkembangan Tumbuhan Seperti telah kita pelajari sebelumnya hormon diproduksi dalam tubuh tumbuhan tetapi dipengaruhi oleh kondisi eksternal lingkungan. Suhu Suhu merupakan faktor lingkungan yang penting bagi tumbuhan karena berhubungan dengan kemampuan melakukan fotosintesis translokasi respirasi dan transpirasi.
 Source: ekosistem.co.id
Source: ekosistem.co.id
Mikrobia dalam pertumbuhannya dipengaruhi oleh beberapa faktor baik faktor fisik kimia maupun biologi. Dalam artikel ini akan membahas lebih rinci faktor dalam yang memperngaruhi pertumbuhan dan perkembangan. Hormon yang mempengaruhi pertumbuhan dan perkembangan pada tanaman ada beragam jenisnya. Suhu Suhu merupakan faktor lingkungan yang penting bagi tumbuhan karena berhubungan dengan kemampuan melakukan fotosintesis translokasi respirasi dan transpirasi. Faktor Luar Eksternal Faktor luar akan memengaruhi pertumbuhan dan perkembangan.
 Source: rumuspelajaran.com
Source: rumuspelajaran.com
Berikut faktor faktor luar yang memengaruhi pertumbuhan. Faktor tersebut dapat dikelompokkan menjadi dua yaitu faktor luar eksternal dan faktor dalam internal. Memang sikap masyarakat ini seringkali dilupakan atau dianggap enteng tetapi tidak jarang pula sikap masyarakat yang kurang dipertimbangkan akan dapat menimbulkan suatu hambatan utama dalam pencapaian sasaran. Gen Gen memengaruhi ciri-ciri dan sifat makhluk hidup. Hal ini terutama faktor dari luar atau faktor lingkungan.
 Source: slideshare.net
Source: slideshare.net
Faktor tersebut dapat dikelompokkan menjadi dua yaitu faktor luar eksternal dan faktor dalam internal. Faktor eksternal tersebut antara lain zat hara cahaya air suhu oksigen dan kelembapan. Faktor Luar Eksternal Faktor yang Mempengaruhi Pertumbuhan dan Perkembangan Makhluk Hidup Faktor internal dan eksternal yang mempengaruhi pertumbuhan dan perkembangan makhluk hidup adalah suhu cahaya kelembaban oksigen air zat mineral hormon genetik dan aktivitas tubuh. Berikut faktor faktor luar yang memengaruhi pertumbuhan. Aktivitas makhluk hidup juga ikut mempengaruhi pertumbuhan dan perkembangan.
This site is an open community for users to do sharing their favorite wallpapers on the internet, all images or pictures in this website are for personal wallpaper use only, it is stricly prohibited to use this wallpaper for commercial purposes, if you are the author and find this image is shared without your permission, please kindly raise a DMCA report to Us.
If you find this site value, please support us by sharing this posts to your favorite social media accounts like Facebook, Instagram and so on or you can also save this blog page with the title faktor luar yang mempengaruhi pertumbuhan by using Ctrl + D for devices a laptop with a Windows operating system or Command + D for laptops with an Apple operating system. If you use a smartphone, you can also use the drawer menu of the browser you are using. Whether it’s a Windows, Mac, iOS or Android operating system, you will still be able to bookmark this website.





